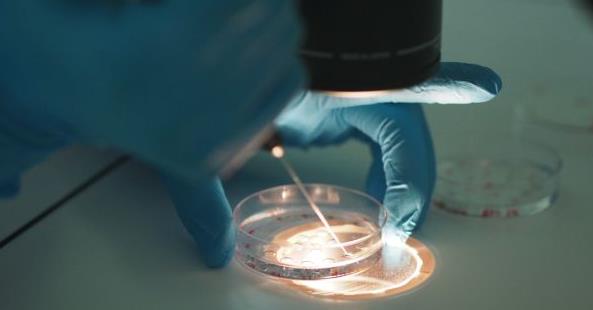
2022年湖州市妇幼保健院做试管婴儿包生男孩价格多少？

-
湖州市妇幼保健院试管婴儿多少钱,2023费用清单实例参考
湖州妇幼保健院(浙江省湖州市妇幼保健院)成立于1951年,是一所集医疗、教学、科研为一体的妇幼保健院,院内目前开设有小儿妇科、妇科、产科、新生儿科、生殖医学科等,很..
2023-05-06 12:56 -
2022年湖州市妇幼保健院做试管婴儿包生男孩价格多少?
2022年湖州市妇幼保健院做试管婴儿包生男孩价格多少?湖州市妇幼保健院,也可以叫湖州市妇女儿童医院,成立于1951年。是三级甲等妇幼保健院,浙江省第七家开展辅助生殖技术..
2023-06-19 11:24 -

2023年湖州市妇幼保健院做二代试管婴儿包生男孩价格多少?
2023年湖州市妇幼保健院做包价格多少?湖州市妇幼保健院,也可以叫湖州市妇女儿童医院,成立于1951年。是三级甲等妇幼保健院,浙江省第七家开展辅助生殖技术的医院。2009年..
2023-07-19 12:12 -

湖州市妇幼保健院做第二代试管婴儿经验总结分享
备孕3年,都没有怀孕,后来检查发现我有多囊卵巢综合征,通过治疗和调理依然没有怀孕。最终到湖州市妇幼保健院做了二代试管婴儿。在二代试管婴儿的路上也遇到过很多不孕不..
2024-02-17 09:33 -

湖州市妇幼保健院试管婴儿经验总结分享
备孕3年,都没有怀孕,后来检查发现我有多囊卵巢综合征,通过治疗和调理依然没有怀孕。最终到湖州市妇幼保健院做了试管婴儿。在试管婴儿的路上也遇到过很多不孕不育的女生..
2024-03-03 10:23 -

湖州市妇幼保健院第二代试管婴儿 期待好运
经历过二代试管婴儿后,真心觉得所有做二代试管婴儿的女人都很厉害。我是因为多囊卵巢综合征做的二代试管婴儿,在下定决心做二代试管婴儿的那1个月里,我在医院的第一个晚..
2024-04-08 10:08 -

湖州市妇幼保健院
医院简介:湖州市妇幼保健院,创建于1951年2月,是一所集医疗、教学、科研、妇幼保健与计划生育技术指导于一体的三级甲等妇幼保健院,2015年与市计划生育宣传技术指导站实..
2024-08-21 09:31 -

2025年湖州市妇幼保健院做二代试管婴儿包生男孩价格多少?
2023年湖州市妇幼保健院做包价格多少?湖州市妇幼保健院,也可以叫湖州市妇女儿童医院,成立于1951年。是三级甲等妇幼保健院,浙江省第七家开展辅助生殖技术的医院。2009年..
2025-01-06 11:00
微信分享
扫描二维码分享到微信或朋友圈